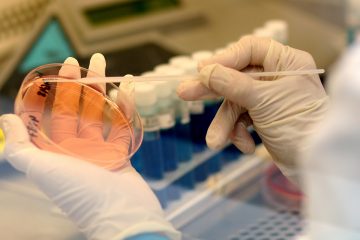
INTEMAN -Biotecnologia

Productos Químicos y Biotecnológicos para mantenimiento industrial
INTEMAN LaboratoriosEmpresa

Somos fabricantes
INTEMAN Laboratorios es una empresa fabricante de productos químicos y biotecnológicos. Contamos con técnicos formados, amplia experiencia y laboratorio propio.
Biotecnologia
Apostamos por la biotecnología: El equipo de profesionales de INTEMAN está formado por químicos y biólogos con conocimientos y experiencia, necesarias para la investigación en productos más eficaces y menos agresivos.
Compra verde
Inteman a través de su familia de productos KENBI te ofrece la oportunidad de adquirir productos que reducen los impactos negativos sobre la salud humana y el medio ambiente, y contribuir así al desarrollo sostenible recomendado por las diversas políticas y directivas europeas.
Innovación
Innovamos continuamente. Somos PYME INNOVADORA. Hemos apostado por la biotecnología. Disponemos de modernos laboratorios para la investigación y desarrollo de nuevos productos.

